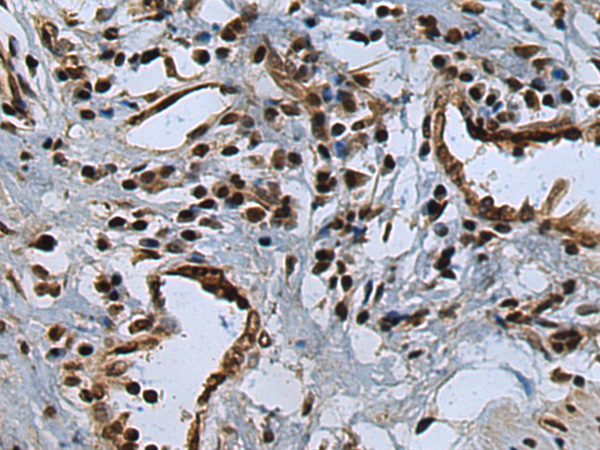

中文名稱: 兔抗APP多克隆抗體
|
Background: |
This gene encodes a cell surface receptor and transmembrane precursor protein that is cleaved by secretases to form a number of peptides. Some of these peptides are secreted and can bind to the acetyltransferase complex APBB1/TIP60 to promote transcriptional activation, while others form the protein basis of the amyloid plaques found in the brains of patients with Alzheimer disease. In addition, two of the peptides are antimicrobial peptides, having been shown to have bacteriocidal and antifungal activities. Mutations in this gene have been implicated in autosomal dominant Alzheimer disease and cerebroarterial amyloidosis (cerebral amyloid angiopathy). Multiple transcript variants encoding several different isoforms have been found for this gene. |
|
Applications: |
ELISA, WB, IHC |
|
Name of antibody: |
APP |
|
Immunogen: |
Synthetic peptide of human APP |
|
Full name: |
amyloid beta precursor protein |
|
Synonyms: |
AAA; AD1; PN2; ABPP; APPI; CVAP; ABETA; PN-II; preA4; CTFgamma |
|
SwissProt: |
P05067 |
|
ELISA Recommended dilution: |
5000-10000 |
|
IHC positive control: |
Human prostate cancer and Human esophagus cancer |
|
IHC Recommend dilution: |
50-100 |
|
WB Predicted band size: |
87 kDa |
|
WB Positive control: |
Raji and Jurkat cell lysates |
|
WB Recommended dilution: |
1000-5000 |

購(gòu)物車
購(gòu)物車 幫助
幫助
 021-54845833/15800441009
021-54845833/15800441009
